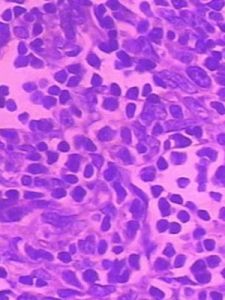

臨床表現
胸腺瘤的臨床症狀產生於對周圍器官的壓迫和腫瘤本身特有的症狀——合併綜合徵。小的胸腺瘤多無症狀,也不易被發現。腫瘤生長到一定體積時,常有的症狀是胸痛、胸悶、咳嗽及前胸部不適。症狀遷延時久,部分患者行X線檢查或某些患者在查體胸透或攝胸片時發現縱隔腫物陰影。被忽略診斷的胸腺瘤此時常生長到相當大體積,壓迫無名靜脈或有上腔靜脈梗阻綜合徵的表現。劇烈胸痛,短期內症狀迅速加重,嚴重刺激性咳嗽,胸腔積液所致呼吸困難,心包積液引起心慌氣短,周身關節骨骼疼痛,均提示惡性胸腺瘤的可能。
胸腺瘤特有的表現是合併某些綜合徵,如重症肌無力、單純紅細胞再生障礙性貧血、低球蛋白血症、腎炎腎病綜合徵、類風濕性關節炎、紅斑狼瘡、巨食管症等。
檢查
1.X線檢查
可以顯示縱隔增寬,前縱隔腫物影像,並可了解心臟影有無增大,肺組織有無浸潤。
2.胸部CT或MRI檢查
有助於了解腫瘤侵犯範圍、大小和心包情況,以利於分期和制定治療方案。
3.病理活檢
治療前活檢做組織學分類是必要的,因為縱隔腫瘤種類很多,簡單方法是,用針刺做細胞學檢查或特殊空針穿取組織學分類更好。必要的開胸探查取冰凍組織學檢查的同時,決定可否施行手術。
診斷
X線檢查是發現及診斷縱隔腫瘤的重要方法。胸部平片正位相,胸腺瘤常表現為一側隔增寬或突向一側胸腔的圓形或橢圓形緻密影,突向右側多於左側,也可見突向雙側胸腔。
胸部CT是先進而敏感的檢查縱隔腫瘤的方法,它能準確地顯示腫瘤的部位、大小、突向一側還是雙側、腫瘤的邊緣、有無周圍浸潤以及外科可切除性的判斷。
鑑別診斷
需要與胸腺瘤鑑別的病變包括畸胎瘤和升主動脈瘤。畸胎瘤常發生在中青年,可無症狀,或有反覆發作的肺部感染,有時有咳出毛髮或油脂樣物的病史,X線檢查腫塊內可有牙齒或骨骼鈣化影,囊性畸胎瘤經超音波檢查予以確定。
縱隔腫瘤誤認為升主動脈瘤,或將升主動脈瘤誤診斷為胸腺瘤均有發生。在胸部側位相升主動脈瘤呈梭形、圓形陰影,沿自左心室,胸透可見腫塊呈膨脹性搏動,聽診可聞及雜音,二維超聲檢查可發現升主動脈擴張,彩色都卜勒檢查可見湍流頻譜,胸部CT像可顯示升主動脈局限性瘤樣擴張。診斷有困難時可行升主動脈造影。
近年來MRI在臨床上套用逐漸增多,對於心臟大血管畸形及血管瘤的診斷有特殊的價值,是區分縱隔腫瘤與升(降)主動脈瘤敏感而有效的檢查方法。
併發症
1.重症肌無力
長期以來人們即發現重症肌無力與胸腺(或胸腺瘤)有關。重症肌無力臨床上可分為3型,如眼瞼下垂、視物長久疲勞、復視等為眼肌型;上肢伸舉不能持久、步行稍遠需坐下休息為軀幹型;咀嚼吞咽費力,甚至呼吸肌麻痹為延髓型。臨床上最危險的是肌無力危象,患者呼吸肌麻痹必須人工輔助呼吸。
目前認為重症肌無力是一自身免疫性疾病,主要因胸腺受某種刺激發生突變,多年來一直採用抗乙醯膽鹼酯酶藥物治療重症肌無力,如吡啶斯的明,近年來又加用免疫抑制劑,如激素、環磷醯胺等。
2.單純紅細胞再生障礙性貧血
與胸腺瘤並存疾病之一是單純紅細胞再生障礙性貧血。純紅再障可為原發的,原因不清,也可繼發於藥物、感染和腫瘤。
3.腎病綜合徵腎炎
腎病綜合徵腎炎與胸腺瘤的關係尚不明了。腎病綜合徵可以是某些腫瘤,如霍奇金病全身表現的一部分。可能的解釋是,胸腺瘤與腎小球腎炎的抗原抗體複合物形成交叉反應。
治療
1.治療原則
胸腺瘤一經診斷即應外科手術切除。無論良性或惡性胸腺瘤都應儘早切除。切除的惡性胸腺瘤可取病理活檢指導術後治療,部分切除者術後放射治療可緩解症狀,延長患者存活時間。
2.手術時應注意的問題
孤立無粘連的良性胸腺瘤,完整摘除無困難,手術可順利完成,但某些複雜病例手術時要充分估計困難。惡性胸腺瘤須先探查,搞清腫瘤與周圍鄰近器官的關係再行解剖。胸腺瘤位於縱隔心底部,心臟與大血管交界處;惡性胸腺瘤向周圍粘連浸潤;腫瘤增長時鄰近組織器官被推移,正常解剖關係改變;纖維結締組織粘連增厚,使之與血管不易辨別,這些均可造成術中誤傷血管而引起大出血。
預防
本病無有效預防措施,早診斷早治療是本病的防治關鍵。同時應注意防止各種併發症的發生,一旦出現則應該積極治療,防止疾病進一步發展。